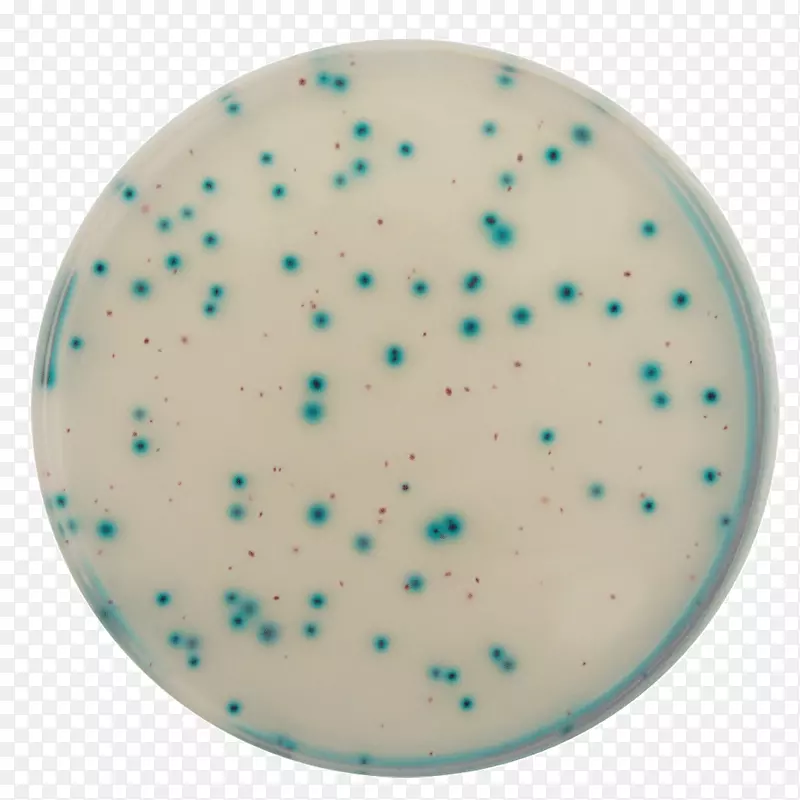
��������ˮ�ּ�����ˮ��ѧ΢����ѧ-ˮ-������

欢迎您 本站地址:
首页
图片素材
生长介质水分检测分析水化学微生物学-水-图片素材分享-空若网

图片素材推荐-空若网

套索电脑图标字体-套索

眼镜,蓝色眼镜,水镜

水彩画 油漆 湿墨水

商标桌面壁纸绿松石.设计

天使色 水绿色 绿松石色

肩袖水绿松石-水

轮圈运动圈

剪贴画太阳能水消毒图像瓶-水

塑料储罐蓄水池水

玉水雨滴-淡水水滴

相框 矩形 水族

绿松石-苏菲

社交媒体图标 浅绿色 蓝色

手袋蓝色绿色金属拉链

商标桌面壁纸.设计

标志产品设计品牌字体-钻石供应公司徽标字体

标志品牌设计

蓝天水-应用Skype 2

绿松石色 水绿色 电蓝色

标志图案设计品牌水

友谊图标 绿松石色 浅绿色

浅绿色 绿松石色 电蓝色

商标字体-你做到了

浴室图标 清洁图标 必需品图标

商标字体设计

绿松石泰尔商标桌面壁纸.研究

杯水放大镜餐具.预览2

清洁图标 毛巾图标 绿松石
温馨提示 扫描下方二维码,访问手机版。